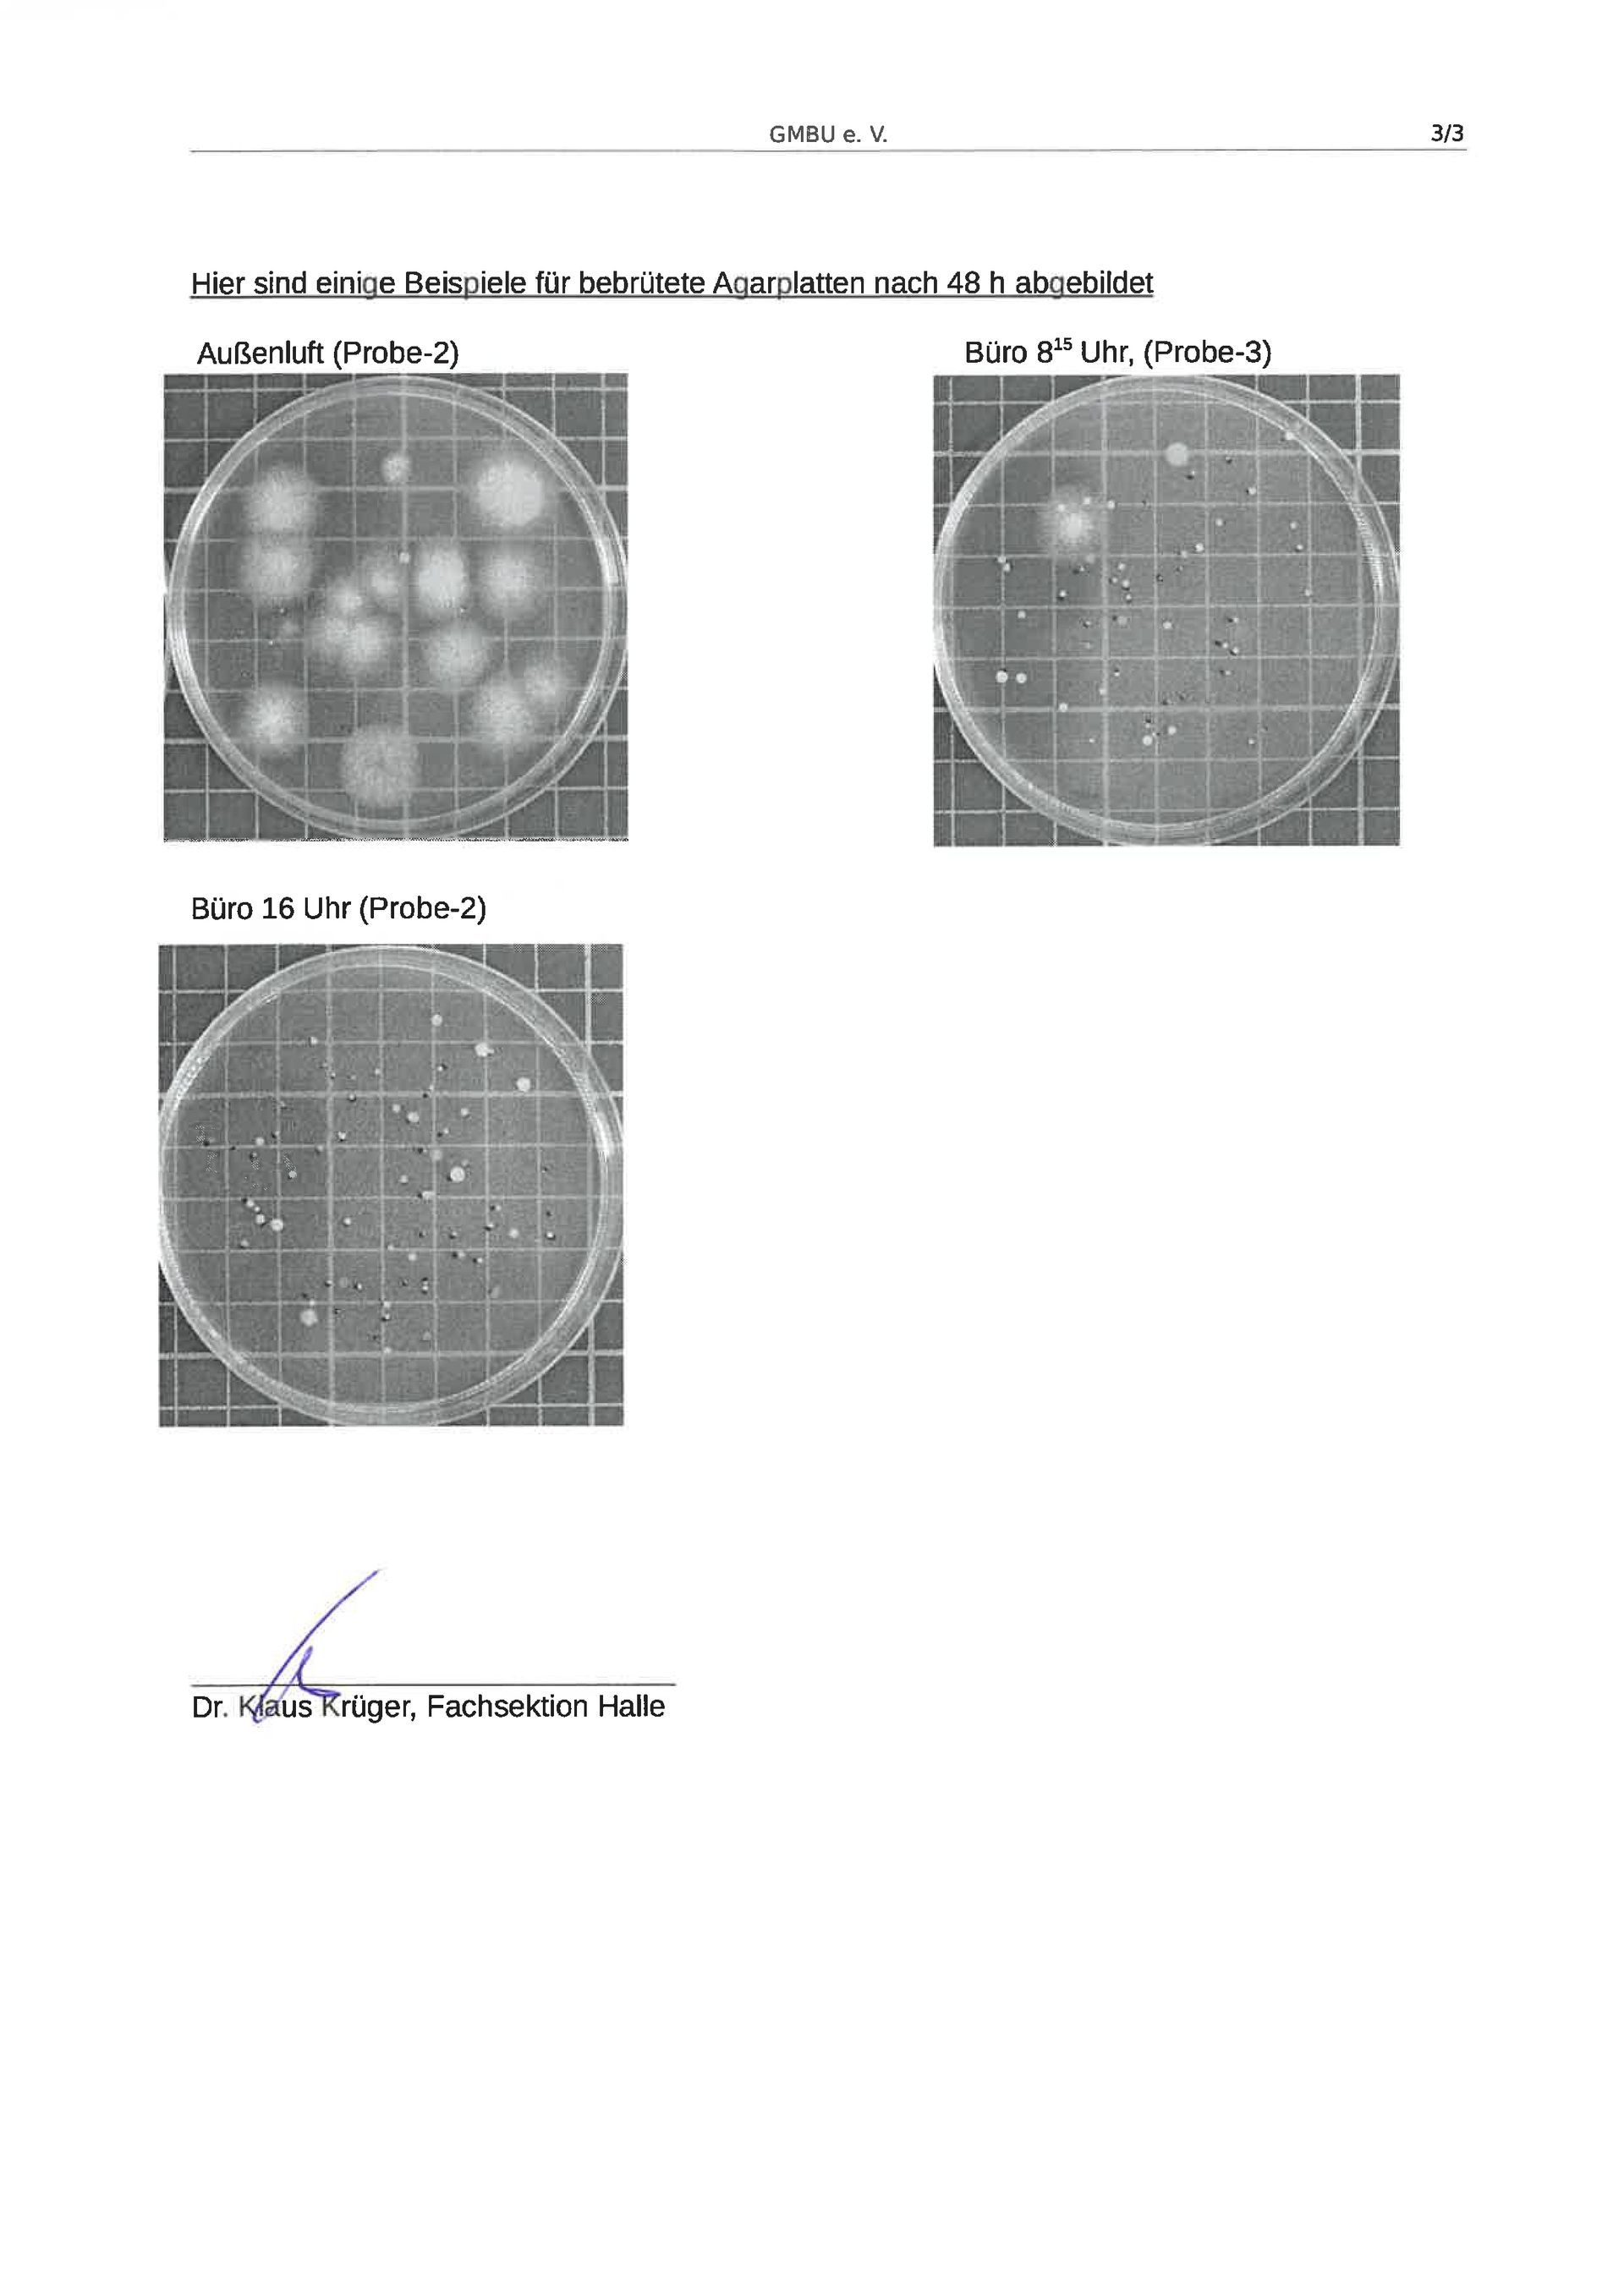
Meeresklimagerät, Meeresluft für Zuhause, Luftreiniger, Luftbefeuchter, Mineralien in der Luft, saubere Luft, reine Luft, Asthma, Allergien, COPD, Krupphusten, verstopfte Nase nachts, was hilft bei Asthma, was hilft bei Allergie, Sauerstoff Therapie, Sole inhalieren, richtig inhalieren, Salz inhalieren, Salz Sole selber machen, Salz Sole kaufen, was hilft bei Krupphusten, Krupphusten bei Kindern, Solegrotte Zuhause, Salzgrotte in der Nähe, Kuraufenthalt am Meer, Meeresluft für Asthma, Meeresluft für COPD, Meeresluft bei Allergien, Desensibilisierung bei Allergien, AIRnessi Meeresklimagerät, Lüfter für Schlafzimmer und Wohnzimmer, Lüfter für Büro, Lüfter extra leise, Klimagerät extra leise

Labor Bericht
Labor Bericht
Lesen Sie nachfolgend den Labor-Bericht, zur Untersuchung der Keim- und Feinstaubreduzierung in der Raumluft, mit Hilfe unseres AIRnessi-Meeresklimagerätes und unserer speziell entwickelten AIRbound-Sole.
Mit dem AIRbound-Raumluftsystem wird die Keimbelastung in der Luft nachweislich um bis zu 87 % gesenkt. Aufgrund des hohen Salzgehaltes in der Luft und im Behälter des AIRnessi-Meeresklimagerätes, haben Viren, Bakterien und Pilze keinen Untergrund um anzuhaften und sich zu vermehren.
Erfahren Sie mehr über das AIRbound-Raumluftsystem und entdecken Sie unsere Vorteile.
Lesen Sie nachfolgend den Labor-Bericht, zur Untersuchung der Keim- und Feinstaubreduzierung in der Raumluft, mit Hilfe unseres AIRnessi-Meeresklimagerätes und unserer speziell entwickelten AIRbound-Sole.
Mit dem AIRbound-Raumluftsystem wird die Keimbelastung in der Luft nachweislich um bis zu 87 % gesenkt. Aufgrund des hohen Salzgehaltes in der Luft und im Behälter des AIRnessi-Meeresklimagerätes, haben Viren, Bakterien und Pilze keinen Untergrund um anzuhaften und sich zu vermehren.
Erfahren Sie mehr über das AIRbound-Raumluftsystem und entdecken Sie unsere Vorteile.